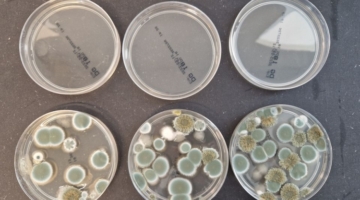

Droner fra den danske virksomhed Drone Systems flyver om natten og kan via varmefølsomme kameraer opdage varmelækager fra fjernvarmerør i jorden. Og dem er der en .

Varmere vejr betyder mindre indtægter til Hofor – derfor stiger prisen allerede nu
Aktuelt20. 10. 2025
Vejret har været dejligt og lunt i 2025. Det betyder et mindre forbrug af fjernvarmen, og dermed færre indtægter til Hofor, Hovedstadsområdets Forsyningsselskab. Men omkostningerne til at vedligeholde rør og levere varmen er de samme, og derfor er man nødt til at hæve prisen med tre procent til november for at sikre fortsat balance mellem […]
UVC-teknologi skal beskytte hospitaler mod skimmel og give bedre indeklima
Aktuelt20. 10. 2025
Skimmel i hospitalsbygninger er et voksende problem, der truer både patientsikkerheden og bygningsdriften. Fugt, ventilationssystemer og ældre konstruktioner skaber ideelle forhold for vækst af skimmelsvamp, som kan have alvorlige konsekvenser for patienter med svækket immunforsvar. Nu bliver den internationalt anerkendte Far-UVC 222 nm teknologi tilgængelig i Danmark gennem den danske virksomhed UV Medico, som bringer […]
Sproget kan være en hjælp for den grønne omstilling – eller en regulær stopklods
AktueltBæredygtigt byggeri17. 10. 2025
Kommunikation er altafgørende, hvis man vil nå ud til store grupper i befolkningen. Det rigtige sprog skubber på, mens det forkerte sprog, forkerte ord eller fagudtryk kan være en regulær stopklods for selv de bedste initiativer. Netop sprog, byggebranchen og den grønne omstilling er
Finans Danmark vil have fjernet regulatoriske barrierer for at få fart i de grønne projekter
Energi16. 10. 2025
Regler, uklare rammer og usikkerhed udgør en barriere for mange projekter for nye grønne teknologier, der skal hjælpe med at nå klimamålet om CO2-neutralitet i 2050. Finans Danmark kommer med en række anbefalinger, der fjerner regulatoriske barrierer og give bedre rammevilkår, så finansieringen
/Nyheder
- Sponsoreret indhold
- SA Klima og Fugtteknik ApS
-
19-05-2025
Fugtkontrol sikrer fødevareproduktion ›
- Schneider Electric Danmark
- Brødrene Dahl
- Building Green
- METRO THERM A/S
- Building Green
-
15-05-2025
Kun 1 uge til VVS-messen – er du klar? ›
-
15-05-2025
Mød METRO THERM på VVS-messen ›
Nyt omfattende naturprojekt i Solrød er på plads – samtænker mange interesser
Nyt, stort naturprojekt i Solrød Kommune er nu på plads. Det viser, at det er muligt at samtænke mange interesser i ét område, der både beskytter drikkevandet, styrker naturen, hjælper klimaet og giver borgerne rekreative friluftsmuligheder. Det cirka 140 hektar store projekt ligger ved
Lemvigh-Müllers håndværkerbutik i Sønderborg har fået ny chef – og et nyt mål
Navne15. 10. 2025
Den 1. september tiltrådte Martin Svendsen som ny butikschef i Lemvigh-Müllers håndværkerbutik i Sønderborg. Martin er et velkendt ansigt blandt områdets håndværkere. Han kommer fra en stilling som butikschef hos konkurrenten Brdr. Dahl i Sønderborg, hvor han de seneste tre år har stået i spidsen
Hos KORN180 giver man DIN Forsynings slidte arbejdstøj et nyt liv
AktueltBrancheNyt15. 10. 2025
Medarbejderne hos DIN Forsyning har et stort forbrug af arbejdstøj. Og trods det orange tøj er slidstærk, holder det ikke evigt. I stedet for blot at smide det ud, får det nyt liv hos KORN180 - Bennys bukser bliver til Torkilds taske, mens tøj, der stadig er brugbart, bliver genbrugt, som det
Dansk forbrug af biomasse er stigende – især biogas og skovflis er steget de seneste fem år
Vedvarende energi udgjorde over 48 procent af det samlede energiforbrug i Danmark i 2024. Den største del, 64 procent, stod biomassen for. Især brugen af biogas og skovflis er stigende, vise tal fra Danmarks Statistik. - Vores forbrug af biomasse er steget sidste år, og det ligger nu på det
Lemvigh-Müller slår dørene op til en ny håndværkerbutik i Sønderborg
Navne13. 10. 2025
Lemvigh-Müller har åbnet dørene til en helt ny håndværkerbutik i Sønderborg. Den nye butik rummer næsten 1.000 kvadratmeter butikslokale og et samlet lejemål på 1.280 kvadratmeter. Dermed er der plads til et endnu bredere sortiment på hele 11.000 varenumre. - Udgangspunktet har været at skabe den